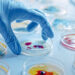
Can We Use Microbes to Colonize Space?

The night sky has played an important role in travel, building, and mythology since humans first entered the world. Sailors have used the night sky to travel great distances under the watchful guide of the stars. The Egyptians and many other civilizations have used the constellations to guide the construction of the pyramids. The Greeks found all of their Gods hidden in the stars through the different constellations we know today. The most important star for many years has been the North Star.
The North Star has proved incredibly useful as if you are ever lost you can use the North star to find your way home. Once you know the North Star you know North, from there everything else, is easy to work out. There is plenty of evidence that people have been using the stars as their guide for centuries from stories in the bible to records in the sailor’s logs.
The star is useful because it is a cepheid. This means that the brightness and size of the star are relatively unchanging. That consistency makes it easier to find. Many people say that it is the brightest star in the sky but this sadly isn’t true. If you try and find the North star based on the brightness you will likely become very confused very quickly. There are many stars almost as bright as the North star and many that are actually brighter. In fact, the North star is only the 50th brightest object in our sky. Meaning if you are looking for the brightest item, you are likely not looking North.
The North star is very easy to find. The Big Dipper is the key. The Big Dipper is one of the easiest constellations to find in the sky. It goes by many names. You may know it as the plough, or the saucepan, the great wagon, or even saptarishi. Whatever you call it, you can spot the Big Dipper because it looks like a saucepan with a long handle. Depending on where you are situated in the world you will see the Little Dipper close by. It may be beside, below, or on top of the Big Dipper depending on your orientation. Again it is easy to spot because it looks like a smaller saucepan. The North Star is the first star on the handle of the Little Dipper and is found directly in line with the tip of the front of the saucepan of the Big Dipper. Easy.
Once you have found the North star we are confident you can find your way home. Scientists used to also believe that they could rely on the North star to map a lot of space but it may be more difficult than they realized. Based on how bright a star shines and how big it is you can usually work out its distance. However, the North Star has surprised many by showing different results. In one measurement it appeared to be 3.45 times brighter than the sun, on a second measure it was 7.5 times brighter.
Scientists now think that the North Star is simply too bright for some devices to measure its brightness. This suggests that we may be registering the limit on our brightness measures and possibly don’t know how bright the star actually is.
If you are planning on living a while longer you should be warned that the North Star won’t always point North. It is expected to move away in about 3,000 years. The North Star is actually called Polaris and it only got the job of North Star 3,000 years ago. Before that, it was a star called Thuban, once that moved off North, Polaris was chosen. While Thuban helped the Egyptians, and Polaris helps us, there is a star named Gamma Cephei that will help the people of the future.